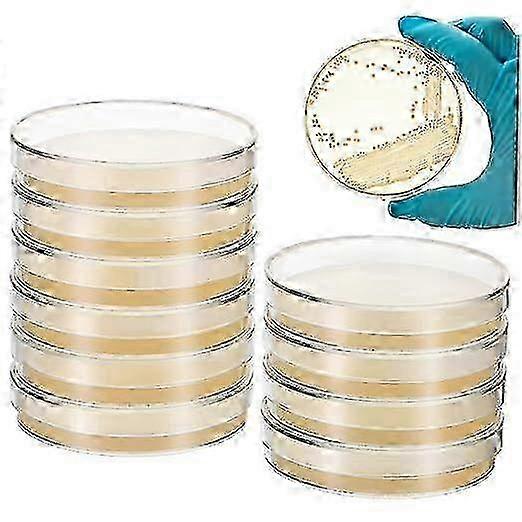

50PCS Agar Petri Dishes: 70mm Sciences Nutrient Agar Petri Dishes Pre-Poured Plates Laboratory Experiment Prepoured Supplies for Science Pro
+ 7 799,00 Ft szállítási költség
50PCS Agar Petri Dishes: 70mm Sciences Nutrient Agar Petri Dishes Pre-Poured Plates Laboratory Experiment Prepoured Supplies for Science Pro
- Márka: Unbranded
50PCS Agar Petri Dishes: 70mm Sciences Nutrient Agar Petri Dishes Pre-Poured Plates Laboratory Experiment Prepoured Supplies for Science Pro
- Márka: Unbranded
Megtakarítás 11 700,00 Ft (47%)
RRP
14 napos visszaküldési szabályzat
Megtakarítás 11 700,00 Ft (47%)
RRP
14 napos visszaküldési szabályzat
Fizetési módok:
Leírás
50PCS Agar Petri Dishes: 70mm Sciences Nutrient Agar Petri Dishes Pre-Poured Plates Laboratory Experiment Prepoured Supplies for Science Pro
- Márka: Unbranded
- Kategória: Petri csészék
- Fruugo azonosító: 444090320-932645741
- EAN: 8265789880362
Kiszállítás és visszaküldés
Kiküldés 2 napon belül
-
STANDARD: 7 799,00 Ft - közötti szállítás H 05 január 2026–H 12 január 2026
Szállítás innen: Kína.
Minden tőlünk telhetőt megteszünk annak biztosítására, hogy rendelését hiánytalanul és előírásainknak megfelelően szállítás ki önnek. Viszont ha egy hiányos rendelést kap, vagy eltér a megrendelttől, vagy bármilyen más okból nem elégedett a rendeléssel, akkor visszaküldheti a rendelést vagy a rendelésben lévő bármely terméket, és visszatérítik a termék árának teljes összegét. Teljes visszaküldési irányelvek megtekintése.
Termékmegfelelőségi részletek
Kérjük, tekintse meg a termékre vonatkozó megfelelőségi információkat az alábbiakban.
Az alábbi információkat a terméket értékesítő független, harmadik fél kiskereskedő biztosítja.
Gyártó:
Az alábbiakban olvashatók a Fruugo platformján értékesített releváns termék gyártójának elérhetőségei.
- jinghang-3
- Hengyang Lengfei Trading Co., Ltd
- Room 1068, No. 52, Yancheng Road, Yueping Community, Tianmashan Street
- Hengyang
- CN
- 421001
- 15927774176@163.com
- 17722821631
Felelős személy az EU-ban:
Az alábbiakban olvashatók az Európai Unióban kijelölt felelős személy elérhetőségei. A felelős személy az az Európai Unióban székhellyel rendelkező gazdasági társaság, amely az Európai Unióban eladott releváns termékekhez kapcsolódó megfelelőségi kötelezettségekért felel.
- Jean Luc
- In Memoria Futuri SAS
- 3 RUE DU PAS DE LA MULE 75004 PARIS
- Paris
- FR
- 75004
- infoapexchen@gmail.com
- 33 745713901

